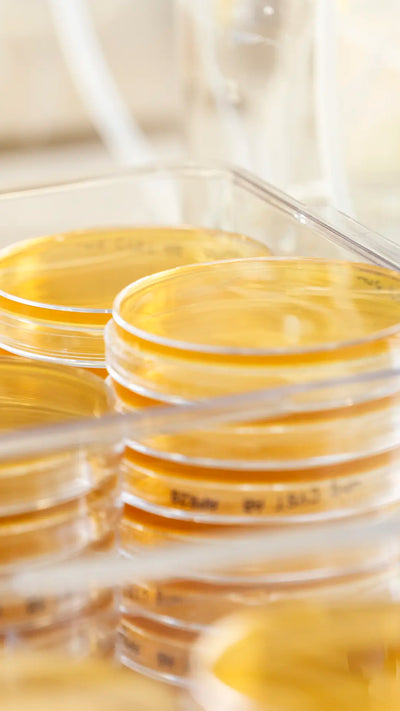
Lactobacillus

Skincare Test

Why choose this probiotic ointment?
- Clinically tested, patented probiotic L. reuteri Aldermis™
- Supports the skin barrier and natural microbiome
- Helps soothe and hydrate delicate skin
- Ideal for dry, sensitive and atopic-prone skin
- Hypoallergenic, dermatologically tested
- Made with skin-loving organic ingredients
- Stable, active probiotics with LongevityGuard™
Only Four Ingredients. No Water. No Fragrance. No Compromise.
Lactobacillus
Clinically tested, patented probiotic, Limosilactobacillus reuteri (L. reuteri Protectis®)

Shea Butter
Softens skin and provides a base for the probiotic.

Canola Oil
Minimizes pores and improves skin texture.

Hydrogenated Rapeseed Oil
Reduces fine lines and promotes cell renewal.
Real Stories from Real Parents
Powered by our patented live L. reuteri Protectis® strain, our Probiotic Ointment is one of the few skincare products formulated with clinically studied live probiotics to help restore harmony to the skin’s natural microbiome. These real parent stories reflect the visible comfort, softness and balance their little ones experienced after introducing the ointment into their daily routine.
Our Bestsellers

Cleanse
A microbiome-friendly balm-to-milk baby wash.
Gently cleanses without stripping and supports the skin's natural balance.
View product
Hydrate
Lightweight moisture for delicate skin.
Nourishes and comforts while helping maintain a balanced microbiome.
View product
Cleanse, Hydrate, Repair
Th full BioGaia Ritual featuring all 3 products from our range.
Supports the skin barrier with live probiotics for calmer, healthier-feeling skin.
View productThe Power of Probiotics
Think of probiotics as living allies for your baby’s skin. These beneficial bacteria help strengthen the skin’s natural barrier, support balance in the skin microbiome, and reduce dryness, redness, and irritation.
xxx
xxx
xxx




